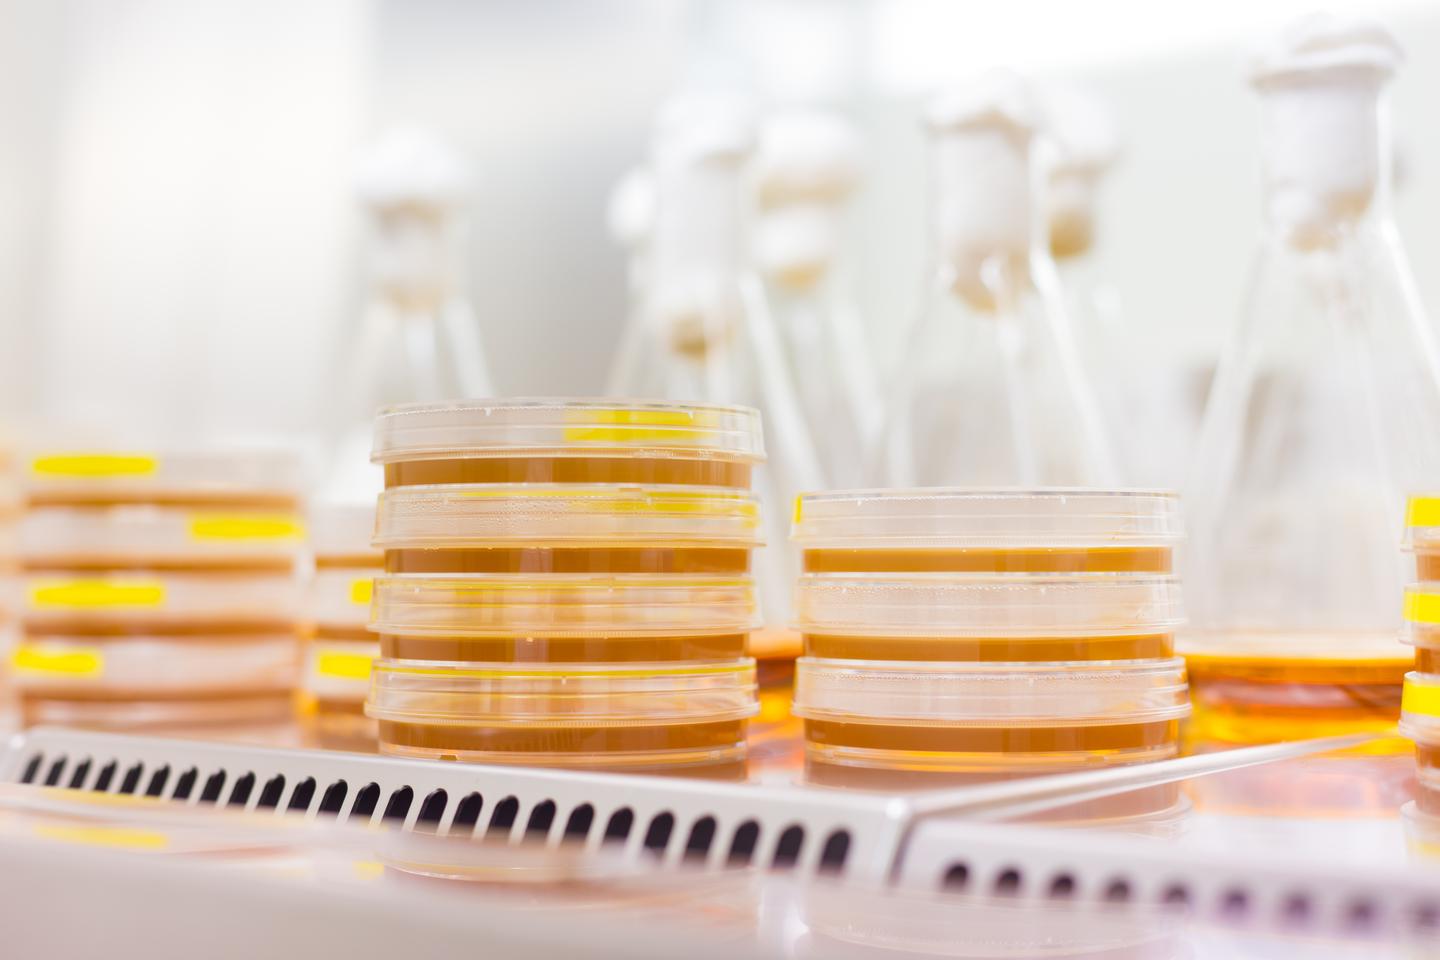

资源中心
细胞实验中,细胞培养常见的几大误区!
时间:2025-01-12 09:02:22点击量:299次
做过细胞实验的人应该都知道,我们在细胞培养过程中时常会出现这样或那样的问题,也会有人存在一些思想误区,比如下面几个。
误区一:别人家实验室培养细胞用的也是这个培养基,我用一样的就可以!
解析:细胞实验中的细胞培养环节,其实选择培养基没有一定的标准,但有几点建议可供参考,最好是建立该细胞株所用的培养基,其次可以参考文献,也可以用实验室常用的培养基进行尝试,当然最重要的还是根据细胞株的特点、实验的需要来选择,如果不嫌麻烦的话,可以用多种培养基培养,根据实际效果选择。
误区二:为了对抗污染,细胞培养时连续使用抗生素
解析:细胞培养时不应常规使用抗生素,因为连续使用抗生素会促进抗生素耐药性细胞株的产生,导致轻度污染持续存在,一旦将抗生素从培养基中去除,这种轻度污染最终将发展成大规模污染,那时候后悔都来不及!其次,连续使用抗生素会掩盖支原体感染及其他隐性污染,更有甚者,有些抗生素会与细胞发生交叉反应,干扰你研究的细胞过程,所以不要为了对抗污染,细胞培养时连续使用抗生素了。
误区三:培养基中的谷氨酰胺容易降解,需要不断补充
解析:如果正确使用,一般不需要补加。
误区四:为了省钱,培养基不小心存放到了-20℃的环境下,溶解后还可以继续使用
解析:错,大错特错,在-20℃下,培养基中的盐容易析出,培养基再次融化后,有的盐可能无法重新溶解,从而导致培养基营养成分和渗透压改变,在我们细胞实验中的培养细胞环节时这样做,细胞很容易破裂而死亡,所以不要舍不得,赶紧丢。
当然,关于细胞实验中的细胞培养环节的误区绝不止这4个,你还知道哪些呢~
细胞实验外包 想了解更多请关注:http://www.do-gene.cn

